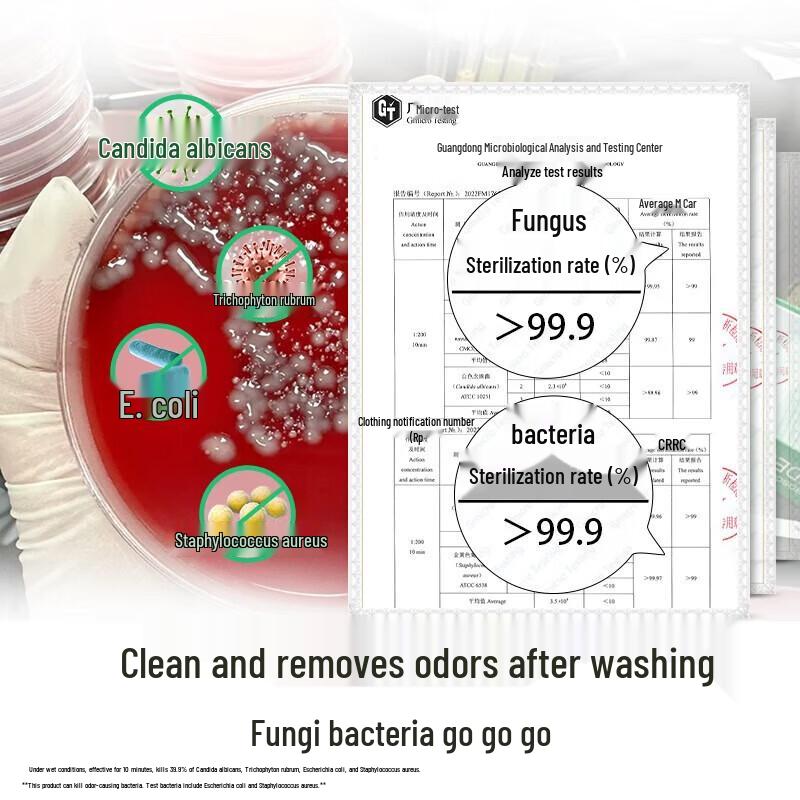
Dettol Foaming Hand Wash & Underwear Disinfectant Bundle

Stránka nepodporuje váš prohlížeč. Aktualizujte prosím svůj prohlížeč nebo si stáhněte jiný

Model
Doručení do ČR 🇨🇿
6–12 pracovních dnů · 85 Kč
Vaše platby a soukromí jsou v bezpečí







Bezpečnost a soulad s předpisy
Vlastnosti
Datum minimální trvanlivosti
3 roky
Popis
JDST online
4,5/2 000+